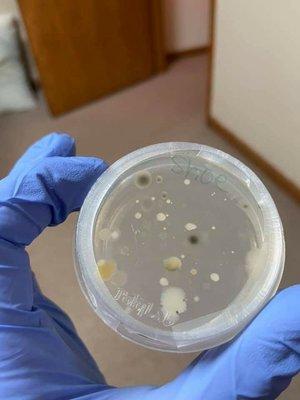
JEMS Cleaning and Janitorial Services

David and his crew are amazing! We started hosting our condo on Airbnb and wanted a reliable cleaning service. Clean Option Services was able to accommodate all of our checklists and our condo is...
Clean Option Services
(1)
Advertisement
Clean Option Services is a locally-owned and operated cleaning company in Longmont, CO, serving residents throughout Colorado. They specialize in providing cleaning services for busy professionals who don't have the time to clean their apartments, homes, and offices, ensuring that properties are kept tidy and germ-free. With their excellent customer service, attention to detail, and 100% satisfaction guarantee, Clean Option Services delivers a consistent 5-star experience, making them the go-to choice for all cleaning needs.
What sets Clean Option Services apart is their responsive approach, addressing any client questions and recommending immediate solutions for additional cleaning. They believe in providing exceptional quality without the need for unnecessary services or long-term contracts. With secure online payment options and a dedicated team, Clean Option Services is committed to delivering a pristine cleaning experience that saves clients valuable time and leaves their properties sparkling.
Generated from the website
You might also like
Advertisement